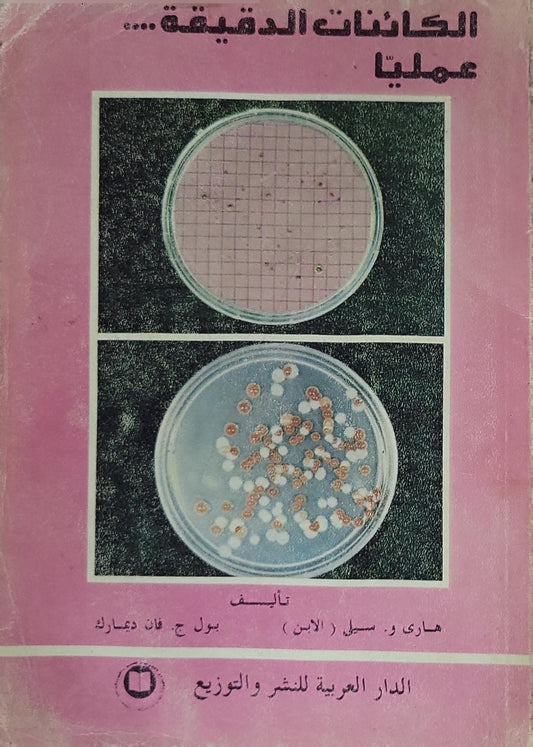
الكائنات الدقيقة... عمليا - هاري و. سيل (الابن) - بول ج. فان ديمارك

-
الكائنات الدقيقة... عمليا - هاري و. سيل (الابن) - بول ج. فان ديمارك
By: هاري و. سيل (الابن), بول ج. فان ديمارك
السعر العادي LE 230.00 EGPالسعر العادي -
الهرمونات النباتية والتطبيقات الزراعية - أ.د/ الشحات نصر أبو زيد
By: أ.د/ الشحات نصر أبو زيد
السعر العادي LE 220.00 EGPالسعر العادي -
بساتين الفاكهة - و. هـ. تشاندلر
By: و. هـ. تشاندلر
السعر العادي LE 420.00 EGPالسعر العاديLE 812.00 EGPسعر البيع LE 420.00 EGPخصم -
تكنولوجيا الزراعات المحمية (الصوبات): سلسلة العلم والممارسة في المحاصيل الزراعية - أ.د. أحمد عبد المنعم حسن
By: أ.د. أحمد عبد المنعم حسن
السعر العادي LE 220.00 EGPالسعر العاديLE 0.00 EGPسعر البيع LE 220.00 EGP -
-
زراعة وإنتاج الفاكهة في الأراضي الجديدة - د. مختار محمد حسن - د. محمد راغب الزناتي
By: د. مختار محمد حسن, د. محمد راغب الزناتي
السعر العادي LE 150.00 EGPالسعر العادي